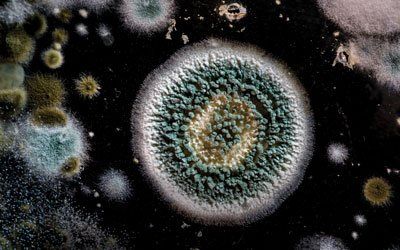
Mold

Allergy Avoidance
One of the most effective treatment plans for some people with allergies is avoidance. (It also happens to have zero side effects!) By simply staying away from your allergy triggers or eliminating them from your environment, you can avoid systemic symptoms. While complete and total avoidance isn't always possible, you can take some steps to at least minimize your exposure. Here are a few of the top allergens and how you can adapt your environment or your routine to improve your symptoms.
House Dust
House dust contains many different particles that can trigger an allergic reaction. One of the most common particles is a protein found in the bodies and feces of dust mites. Dust mites are microscopic, insect-like creatures who thrive off animal and human dander. They live in even the cleanest of homes, though they are less likely to survive in dry climates and at high altitudes. Dust mites can be found predominately in pillows, mattresses, carpet, upholstered furniture, stuffed animals and clothing. The true allergen from the dust mite is not the mite itself but its body proteins and waste particles. Although these particles settle onto surface areas, they are easily disrupted and dispersed into the air whenever we vacuum, move a pillow or hug a stuffed animal, which makes them very easy to inhale and thus trigger an allergic reaction.The bedroom is where we can make the most significant reduction in exposure to dust mites. Since dust mites thrive in pillows and mattresses, use vinyl covers that completely enclose each pillow and the mattress, even on pillows labeled “allergy free,” to create a dust mite barrier. Comfortable vinyl covers (specially designed cloth covers with a urethane backing) that do not interrupt sleep patterns can be purchased at The Allergy, Asthma & Sinus Center. Feather pillows and “down” comforters should be avoided at all costs. Dust mites can be killed and their waste removed by machine washing sheets and pillowcases in the hot cycle (exceeding 130 degrees) and by using a dryer. Sheets and pillowcases should not be dried on a clothesline because mold and pollen will settle onto them. All bedding should be stored in plastic containers or in tightly closed drawers. Carpet presents a big problem in dust mite avoidance. If at all possible, bedroom carpeting should be removed. Studies clearly show that removal of carpet decreases dramatically the exposure to dust mites. If removing carpet is impossible or impractical, it should be vacuumed at least two times a week. Special allergy vacuum bags with tight filters are available. High room humidity not only increases the dust mite’s ability to reproduce, it encourages the growth of mold. Maintain humidity levels at less than 50%; 40% is optimal.
Here are other important dust mite-reducing measures for the bedroom:
- Do not use ceiling fans.
- Close or place a guard over the bedroom vent.
- Remove all stuffed animals and security items. If they have to be used, machine wash them in the hot cycle.
- Freezing them or placing them in the sun will kill the dust mites, but it will not remove their waste. Only washing at temperatures higher than 130 degrees will eliminate both the mite and its byproducts.
- Remove clutter and simplify the area around the headboard and bedside tables. Fewer items collect less dust.
- Dust daily with a damp cloth or a commercial dusting product.
- Bookcase headboards with decorative items should not be used.
- Avoid placing the head of the bed near or against a window.
- Pull the bed away from the wall to vacuum and dust the area once a month.
- Keep closet doors shut.
- Venetian blinds, grass wallpaper and wicker furniture should be avoided. They are difficult to keep dust-free.
Dust avoidance involves active participation by the patient and an understanding of dust mite allergy. By exercising control over your environment, you can help control your allergies.
Pollen
Pollen is produced by plants and is dispersed in the wind. In our geographic area, pollens that cause people the most problems include tree pollen in February through May; grass pollen in April, May and June; and weed pollen from mid-August until the first hard frost. The shape of pollen makes it very easy for the pollen to be spread through the air on windy days. Ragweed pollen has been found as far as 40 miles from its originating site. It is not uncommon for tree, grass and weed pollen to be found in the air as high as two miles up and as far as three miles out to sea. This makes avoidance of pollen very difficult. However, understanding that pollen is dispersed more abundantly in the morning hours and on windy days allows us to plan outdoor activities appropriately. Immediately after a rain the air is relatively clear of pollen; but be aware that the mold content in the air may increase.By knowing the season and the specific months in which you usually have problems, it is easy to plan indoor activities during that time of year. If your problems occur for only six or eight weeks then you should avoid outside activities if at all possible during that time of year. Change clothes after outdoor activities and shower before bedtime to avoid taking pollen to bed with you. Patients should not be outside while grass is being cut; but if it is unavoidable, a mask and shades should be wornto protect the nose and eyes. Use air conditioning in the house at all times, keep the windows up in your car, and use the recycled air button on the car air conditioner. Certain new models of automobiles have pollen free filtration systems—a feature to consider in the purchase of a new automobile. Seasonal pollen cannot be controlled, but exposure to it can be reduced by the use of air conditioning and planning and limiting outdoor activities.
Mold
Mold, a very prevalent organism, forms spores that “pop off” into the air, where they can be inhaled and cause allergy problems. Mold usually grows anywhere there is adequate heat, darkness and moisture.
The mold count is usually highest in the air:
- when the weather is hot and muggy.
- immediately after a rain.
- in barns with hay and mulch.
- in piles of leaves and compost.
- in damp basements and bathrooms.
To avoid mold:
- Stay out of barns where hay is stored.
- Avoid raking leaves.
- Eliminate damp areas around the home.
- Remove mold sources, such as old carpeting and furniture that has gotten wet or has been stored in a moldy environment.
- Clean leaks and flooded areas within 24 hours.
- Do not steam clean carpets or use carpet in the bathroom.
- Clean bathroom surfaces with an oxidizing agent such as diluted chlorine bleach (1 cup Clorox to ½ gallon of water).
- Avoid potted plants, old books and live Christmas trees.
We can never completely avoid mold; however, with knowledge of mold growth and an understanding of mold prevention, avoidance can be properly implemented and can make allergic individuals more comfortable.
Pets
The easiest avoidance measure to take with pet allergies is often the most difficult—either making them an outdoor only pet or rehoming them. (It's completely understandable if this measure is not even considered. In such cases, we recommend immunotherapy.) Pet dander, or dead skin flakes, as well as saliva and urine can cause allergic reactions. Once these particles are in a room, it can take up to two months for a dog to four months for a cat to be eliminated from the home. If the pet is kept in the house, they should at least be excluded from the bedroom. HEPA (high energy particulate air) filters should be used in the bedroom, even if the animal is never in there. Animal dander will find its way into the bedroom from clothing and simple air movement. Keeping pets on a non-carpeted floor and bathing them on a weekly basis will markedly reduce exposure to animal dander, saliva and urine. Washing a cat may be a challenge, but considering the impact allergies can have on someone, any measure to decrease exposure should be taken. Removing an animal from the home is the best method of allergic control, but if keeping the pet is the only option, make sure the animal is bathed regularly and prevented from entering the bedrooms. Avoiding carpet and using air filters will also help.
Other Allergens and Irritants
Cockroach is a frightening word, especially when we consider this as a true allergen. In certain areas of the country, such as South Florida and in housing projects in the Northeast, cockroaches present a significant problem to allergic individuals. Cockroach allergy may well be a major cause of asthma in those settings. Control measures include the use of pesticides and roach traps and keeping food off counters and the floor.Tobacco smoke, while not a true allergen, is an irritant and a prime consideration. It is well established that breathing secondhand smoke causes problems in allergic individuals and others. Smoking should not be allowed in the house, in the car or in the work place. Opening a window does not eliminate smoke sufficiently to make it acceptable. Smoking with an asthmatic in the house is absolutely unacceptable. Reducing your exposure to allergens through avoidance and environmental control is the most basic, cost effective and least invasive treatment an allergic person can have. Take control and actively participate in the management of your allergies.
Because most people spend nearly one-third of each 24-hour day in bed, indoor environmental control measures focus first on the bedroom.
- Enclose pillows in zippered, dust-proof covers. Encase mattresses and box springs in zippered, dust-proof covers. Wash sheets and pillow cases weekly at 130˚F or greater.
- Wash blankets in hot water (130˚F or greater) every two weeks. (Replace wool or down blankets with a material that can withstand repeated hot water washings.)
- Dust around the head of your bed with a commercial dusting product or a damp cloth every day. (It only takes a minute!)
- Remove security items (such as stuffed animals) from the bed and any dust-collecting room decor.
- Use window shades instead of heavy curtains and venetian blinds. Launder curtains frequently if you use them in the room.
- Dust drawers and closets regularly with a damp cloth. A dust and pollen filter mask may be used for housecleaning and making the bed.
- Use wooden or plastic furniture instead of upholstered pieces.
- Keep clothing in a closet with the door shut.
- Air conditioners reduce the heat and humidity that stimulate mite (and mold) growth. Add an electrostatic filter to trap airborne allergens. Use a dehumidifier in a damp basement.
- Maintain relative humidity at 40-50%. (Use a humidity gauge.) Mites grow best at 75-80% relative humidity and cannot live at humidity below 50%. Avoid over humidification in the winter.
- Close hot air vents and/or add electrostatic filters.
- HEPA cleaners can remove airborne dust particles effectively.
- Keep surfaces simple and clean.